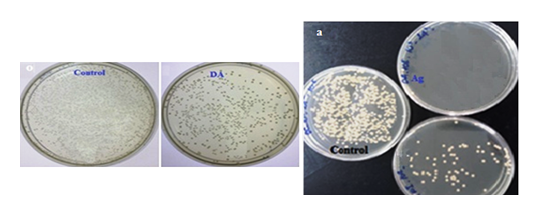

Đề tài Chế tạo và đặc trưng của nanocomposit bạc nano/diatomite do TS. TRƯƠNG THỊ HẠNH (Nghiên cứu viên Viện Tiên tiến Khoa học và Công nghệ - Trường Đại học Văn Lang) thực hiện.
TÓM TẮT:
Nano bạc (AgNPs) có đường kính khoảng 9,2 nm được gắn trên diatomite bằng cách chiếu xạ chùm tia điện tử huyền phù diatomite chứa 10 mM AgNO3 trong dung dịch chitosan 1%, ở liều xạ 20 kGy. Nano composit AgNP/diatomite đặc trưng bởi quang phổ UV-Vis, ảnh chụp SEM, TEM và tán sắc năng lượng tia X. Hoạt tính kháng khuẩn của AgNP/DA chống lại tác nhân gây bệnh cho cá Tra (Pangasianodon hypophthalmus) như Edwardsiella ictaluri đã được đánh giá.
Từ khóa: hoạt tính kháng khuẩn, nanocomposit, nano bạc, chùm tia điện tử, diatomite.
1. Đặt vấn đề
Nuôi trồng thủy sản ở Việt Nam là một trong những ngành kinh tế mũi nhọn có hiệu quả với kim ngạch xuất khẩu cao. Tuy nhiên, việc sử dụng thuốc với hóa chất để khử trùng ao nuôi cá, tôm thường không an toàn cho sức khỏe người sử dụng. Cá ba sa (Pangasianodon hypophthalmus) là một trong những loài cá nuôi xuất khẩu quan trọng ở nước ta. Hiện nay, thách thức đối với người nông dân nuôi cá da trơn là bùng phát dịch bệnh gây thiệt hại lớn về kinh tế. Vi khuẩn và ký sinh trùng đã được xác định là tác nhân gây bệnh chính. Đặc biệt, Aeromonas hydrophila và Edwardsiella ictaluri được coi là những vi khuẩn phổ biến gây chết cá Tra trong ao nuôi. Chế tạo vật liệu mới như nano thay thế hóa chất thông thường có vai trò quan trọng cho sự phát triển môi trường bền vững.
2. Tổng quan nghiên cứu
Nanocomposit được cấu tạo bởi các hạt có kích thước nano trong chất nền polyme hoặc vô cơ (Munir et al., 2023). Những vật liệu này được cải tiến về đặc tính của cả hai thành phần bao gồm các hạt nano và chất nền. Hạt nano nhận được sự quan tâm trong lĩnh vực vật liệu cũng như hóa học bởi khả năng phản ứng với diện tích bề mặt lớn và tính chất hóa lý đồng nhất (He et al., 2014). Đặc biệt, AgNPs được quan tâm bởi hoạt tính kháng khuẩn bên cạnh các tính năng khác. Nó đã ức chế sự phát triển của vi khuẩn, tấn công và phá vỡ màng tế bào vi khuẩn như Staphylococcus aureus (S.aureus), Klebsiella pneumonia (K. pneumoniae), Escherichia coli (E. coli)… (Jone and Hoek, 2010). Diatomite (DA) là vật liệu hấp dẫn cho các ứng dụng công nghiệp vì chi phí thấp, kích thước hạt nhỏ, xốp, ổn định nhiệt và khả năng hấp phụ cao. Sự có mặt của diatomite trong chế phẩm có thể mang lại những đặc tính hữu ích nên nó được sử dụng làm chất trợ lọc, chất cách nhiệt, chất hấp phụ và chất mang (Reza et al., 2015). Nano bạc gắn lên silica hoặc các hợp chất có chứa silica như gốm sứ, montmorillonite, zeolite… đã được sử dụng nhằm mục đích lọc nước như chất diệt khuẩn, chất chống cặn, chất xúc tác và chất khử nhiễm (Pal et al. 2022). Sự phát triển nhanh chóng các chủng kháng thuốc kháng sinh đã nổi lên như một trong những vấn đề nghiêm trọng ảnh hưởng đến sự sống của sinh vật cũng như các loài thủy sinh. Aeromonas hydrophila và Edwardsiella ictaluri kháng lại tetracycline, florfenicol và có khả năng kháng cao với trimethoprim, ampicillin, sulfamethoxazole và cefalexine (Bullock and Roger, 1985). Để giải quyết vấn đề này, một số nghiên cứu chế tạo vật liệu mới kiểm soát các tác nhân lây nhiễm trong môi trường là cần thiết để thay thế cho việc sử dụng kháng sinh. Công nghệ nano đóng vai trò quan trọng trong cho làm tinh nước và hạn chế vi khuẩn gây bệnh cho cá hoặc tôm trong hệ thống nuôi trồng thủy sản (Julio et al., 2018).
Trong nghiên cứu này, AgNPs/Chitosan trên chất nền DA được tạo thành bằng cách chiếu xạ chùm tia điện tử (EB), nhằm khử ion Ag+ hấp phụ trên nhóm SiO- thành phần chính của DA, tạo những nguyên tử Ag đồng thời cố định trên DA. Hoạt tính kháng khuẩn của nanocomposit AgNPs/DA đối với vi khuẩn Edwardsiella ictaluri là tác nhân gây bệnh gan, thận mủ cho cá Tra ở Việt Nam đã được thử nghiệm.
3. Vật liệu và phương pháp
Bột diatomite được mua từ Công ty Cổ phần Khoáng sản Phú Yên có hàm lượng SiO2 trên 63%, cỡ hạt trung bình khoảng10-100µm. Chitosan có mức độ deacetyl hóa khoảng 80% và Mw =1,06×105 như đã chuẩn bị trước đây (Hanh et al. 2023). Các hóa chất khác như bạc nitrat (AgNO3), (S)-lactic axit (90%), natri hydroxit (NaOH) là những tác nhân phân tích. Nước cất đã được sử dụng trong tất cả các thí nghiệm.
4. Phương pháp nghiên cứu
4.1. Chế tạo nanocomposit nano bạc/diatomite bằng phương chiếu xạ chùm tia điện tử
Mẫu DA được ngâm trong dung dịch axit clohydric 3% (v/v) ở nhiệt độ phòng trong 1 h để khử khoáng và được rửa sạch bằng nước cất. Sau đó mẫu được sấy khô ở nhiệt độ 110°C. Tiếp theo, 10 g DA được khuếch tán trong 50 ml AgNO310 mM trong chitosan 1% (w/v, chitosan/axit lactic). Hỗn hợp được khuấy mạnh trong 1 giờ và sau đó huyền phù chứa AgNO3/DA/chitosan được đóng gói trong túi polyethylene có độ dày khoảng 1 cm. Rồi mẫu được chiếu xạ dưới chùm tia điện tử của máy gia tốc tuyến tính UELR-10-15S2 (Nga), năng lượng 10 MeV với dòng điện 1,5 mA ở liều 20 kGy (suất liều 5 kGy/s). Sau đó, huyền phù AgNP/DA được rửa bằng nước cất để loại bỏ tất cả các chất không liên kết khỏi bề mặt. Cuối cùng, mẫu được sấy khô ở 80°C cho các thí nghiệm tiếp theo.
4.2. Đặc trưng của AgNPs/DA
Phổ UV-Vis của dung dịch keo AgNPs được đo trên máy Jasco V-630 từ 200-600 nm, sau khi keo AgNP được tách bằng cách ly tâm huyền phù AgNP/DA. Ảnh TEM của nanocomposit AgNP/DA được thực hiện bằng máy JEOL, JEM-1400 ở 100 kV. Phổ EDX và ảnh SEM được ghi nhận trên thiết bị SEM-EDX - SEM S4800 (Hitachi, Japan) kết hợp phân tích tia X H7593 (Horiba, England).
4.3. Thử nghiệm hoạt tính kháng khuẩn của AgNPs/DA
Hoạt tính kháng khuẩn của AgNP/DA được thử nghiệm với Edwardsiella ictaluri theo tiêu chuẩn (ASTM, Standard E2149, 2010). Vi khuẩn được nuôi cấy trên môi trường thạch Brain Heart Infusion (BHI), sau đó chỉnh huyền phù vi khuẩn ở nồng độ 108 (CFU/mL) bằng cách so sánh độ đục với chuẩn McFarland 0,5. Kế tiếp, 0,26 mg AgNPs/DA được đưa vào trong 100 mL vi khuẩn sau khi pha loãng thành 103-104 (CFU/mL), rồi hỗn hợp được lắc và ủ trong 3 và 24 giờ. Kế tiếp, 0,1 mL dung dịch được rải lên môi trường và ủ ở 30°C trong 24 giờ. Hoạt tính kháng khuẩn (η, %) được đánh giá bằng số lượng khuẩn lạc sống sót trên đĩa BHI:
Trong đó, N0 và N là khuẩn lạc của nước khử trùng (đối chứng) và mẫu thử nghiệm tương ứng, trong 24 giờ (Zhang et al., 2009).
5. Kết quả và thảo luận
5.1. Chế tạo nano bạc bằng phương pháp chiếu xạ
Các ion bạc (Ag+) được hấp phụ trên bề mặt SiO2 của DA và liên kết với nhóm SiO- bằng cách khuấy mạnh tạo thành huyền phù Ag+/SiO2 (DA) trước khi chiếu xạ. Các electron solvate hóa (e-aq) với E° (H2O/e-aq) = - 2,87 V và gốc •H với E° (H+/•H) = - 2.3 V được tạo ra do sự xạ ly của nước có thể khử ion Ag+ thành nguyên tử Ag0 bằng hiệu ứng bức xạ (E°(Ag+/Ag) = - 1,8 V). Sự khử liên tục của ion Ag+ hợp thành “cụm” (cluster) nano bạc (E° (Ag+n/Agn) = 0,79 V) (Linnert và cộng sự, 1990). Hơn nữa, trong dung dịch chitosan, những gốc •OH từ sự xạ ly nước sẽ liên kết với chitosan khử H và tạo gốc đại phân tử (R•1). (Hình 1)
Hình 1: Phổ UV-Vis của keo nano bạc/chitosan từ 10 mM Ag+/chitosan tại 20 kGy
Phổ UV-vis được áp dụng để xác nhận sự khử và chuyển ion Ag+ thành Ag nano bởi kỹ thuật chiếu xạ EB. Màu của dung dịch chiếu xạ chuyển thành màu nâu đậm và bước sóng hấp thụ cực đai của phổ UV-Vis λͅmax = 417 nm trong dải bước sóng từ 200-600 nm. Điều này là kết quả của sự tạo thành nano bạc
5.2. Đặc trưng của AgNP/DA
Hình 2: Ảnh SEM và phổ tán xạ năng lượng tia X của DA (a, b) và AgNP/DA (c, d)
Hình 2 thể hiện ảnh SEM của các mẫu DA và AgNP/DA. Cấu trúc xốp trống của DA thể hiện trong Hình 2a, trong khi hình thái học của AgNP/DA trong Hình 2c chỉ ra sự hiện diện của bạc nano với những chấm trắng sáng trên bề mặt của DA. Thành phần nguyên tố của DA được xác định bằng phổ EDX trong Hình 2b bao gồm các đỉnh O, Na, Al và Si ở mức năng lượng tương ứng 0.5, 1.1, 1.5 và 1.8 keV. Phổ EDX của AgNP/DA mô tả đỉnh mới của Ag ở 3 keV bên cạnh các nguyên tố như DA (Hình 2d). Trọng lượng của AgNPs trong DA được xác định từ kết quả ở thí nghiệm này là 0.11%.
Ảnh TEM trong Hình 3b đã biểu thị nano bạc hình cầu màu tối phân bố đều trên bề mặt chất nền so với ảnh TEM nền trơn DA ở Hình 3a. Kính thước hạt nano xác định theo ảnh TEM là 9,2 nm.
5.3. Họat tính kháng khuẩn của AgNPs/DA
Trong nuôi trồng thủy sản, xử lý bệnh tật nhằm tránh thiệt hại rất khó khăn, bởi tính kháng thuốc tăng lên của các loài khi sử dụng kháng sinh lâu dài. Một giải pháp thay thế khác có thể kiểm soát các mầm bệnh quan trọng từ cá, động vật thân mềm và động vật giáp xác đã được nghiên cứu bởi các nhà khoa học đó là áp dụng công nghệ nano (Swain và cộng sự, 2014). Vật liệu tổng hợp silica/nano bạc có khả năng kháng khuẩn Aliivibrio (Vibrio) salmonicida gây bệnh cho cá ngựa vằn (Dananjaya và cộng sự, 2016). Theo Egger và cộng sự (2009), cấu trúc silica là chất mang thích hợp cho sự gắn kết các tác nhân kháng khuẩn như nano bạc, phân tán các hạt nano đều khắp silica và hạn chế sự phóng thích AgNP, nhờ đó hoạt tính kháng khuẩn hiệu quả lâu dài.
Hình 4: Ảnh thử nghiệm ức chế sự phát triển Ed. ictaluri của DA (o) và AgNP/DA (a)
Trong nghiên cứu này, nanocomposit chứa AgNP cố định trên DA thành phần chính là silica đã được thử nghiệm để xác định hoạt tính kháng khuẩn với chủng Edwardsiella ictaluri, gây bệnh gan thận mủ, được phân lập từ cá Tra nhiễm bệnh trong ao nuôi ở đồng bằng Cửu Long. Trong thí nghiệm này, nồng độ 0,26 mg AgNPs/DA trong 100 mL vi khuẩn hay 2,6 mg/L đã được sử dụng. Sau 3 giờ nuôi cấy vẫn còn một số khuẩn lạc sống sót, tuy nhiên qua 24 giờ, không còn khuẩn lạc nào sống sót trên đĩa petri ủ với AgNPs/DA (Hình 4a) trong khi mật độ khuẩn lạc dày đặc trong đĩa DA và các đĩa đối chứng (control) là nước cất. Cơ chế khử khuẩn AgNP được đề xuất rằng AgNP tương tác với màng vi khuẩn và có thể xâm nhập vào bên trong tế bào dẫn đến tăng tính thấm và rối loạn hô hấp. Các hạt nano bạc có thể xúc tác cho các phản ứng với oxy dẫn đến sản sinh ra các sản phẩm oxy hoạt hóa (ROS) làm tổn thương DNA và phá vỡ cấu trúc tế bào (Jone và Hoek, 2010).
6. Kết luận
AgNP/DA được chế tạo bởi quá trình khử ion Ag+ tạo Ag0 nguyên tử, rồi keo tụ tạo nano bạc cố định lên DA, bằng phương pháp chiếu xạ chùm tia điện tử. Hàm lượng AgNP trong DA khoảng 0,11% khi chiếu xạ huyền phù gồm 10 g DA trong 50 mL AgNO3 10 mM /1% chitosan tại liều xạ 20 kGy. AgNP trong DA được xác nhận bằng quang phổ UV-Vis, ảnh SEM và TEM. Đường kính trung bình của AgNP trên DA được xác định là 9,2 nm. Hoạt tính kháng khuẩn của AgNP/DA chống lại vi khuẩn Edwardsiella ictaluri gây bệnh cho cá Tra được thể hiện bằng khả năng ức chế sự phát triển của vi khuẩn so với mẫu DA và đối chứng.
TÀI LIỆU THAM KHẢO:
1. ASTM Standard E2149 Standard Test Method for Determining the Antimicrobial Activity of Immobilized Antimicrobial Agents Under Dyamic Contact Conditions, ASTM International.
2. Bullock G.L., Roger H.L.(1985). Edwardsiella Infections of Fishes, US Fish & Wildlife Publication, pp. 132.
3. Dananjaya S.H.S., Godahewa G.I., Jayasooriya, G.P.T., et al. (2016). Antimicrobial effects of chitosan silver nano composites (CAgNCs) on fish pathogenic Aliivibrio
(Vibrio) salmonicida, Aquaculture, 450, 422-430.
4. Egger S., Lehmann R.P., Height M., et al. (2009). Antimicrobial properties of a novel silver-silica nanocomposite, Environ. Microbiol., 75 (9), 2973-2976.
5. Hanh T.T., Lan Chi T.N., Luan Q.L. (2023). Synthesis and antifungal activity of copper nanoparticles against Fusarium oxysporum pathogen of plants, Res. Express, 10, 065001.
6. He D., Kacopeiros M., Ikeda-Ohno A., et al. (2014). Optimizing the design and synthesis of supported silver nanoparticles for low cost water disinfection, Sci. Technol., 48 (20), 12320-12326.
7. 7 Munir T., Mahmood A., Peter N., et al. (2023). Structural, morphological and optical properties at various concentration of Ag doped SiO2-NPs via sol gel method for antibacterial and anticancer activities, Surf. Interfaces, 38, 102759.
8. Jone C.M., Hoek E.M.V. (2010). A review of the antibacterial effects of silver
nanomaterials and potential implications for human health and the environment,
Nanopart. Res., 12, 1531-1551.
9. Julio C.M.N., Aida H.P., Maria C.M.D., et al, (2018). Silver nanoparticles application in aquaculture, J. Fish and Aquat. Stud., 6, 5-11.
10. Linnert T., Mulvaney P., Henglein A., et al. (1990). Long-lived nonmetallic silver
clusters in aqueous solution: preparation and photolysis. Am. Chem. Soc., 112 (12),
4657-4664.
11. Pal S., Nisi R., Licciulli A. (2022). Antibacterial Activity of In Situ Generated Silver Nanoparticles in Hybrid Silica Films, Photochem, 2, 479-488.
12. Reza A.P.S., Hasan A.M., Ahmad J.J. et al. (2015). The effect of acid and
thermal treatment on a natural diatomite, Chem, 2 (4), 144-150.
13. Swain P., Nayak S.K., Sasmal A., et al. (2014). Antimicrobial activity of metal based nanoparticles against microbes associated with diseases in aquaculture, World J.
Biotechnol., 30, 2491-2502
14. Zhang F., Wu X., Chen Y., et al. (2009). Application of silver nanoparticles to cotton fabric as an antibacterial textile finish, Fibers Polym.,10, 496-50.
Synthesizing and characterizing the silver nanoparticles /diatomite nanocomposite Ph.D Truong Thi Hanh Science and Technology Advanced Institute, Van Lang University ABSTRACT: Silver nanoparticles (AgNPs) with a diameter of about 9 nm were deposited on diatomite by irradiation under an electron beam of diatomite suspension containing 10 mM AgNO3 in a 1% chitosan solution at a dose of 20.2 kGy. The AgNPs/diatomite nanocomposite was characterized by UV-Vis spectroscopy, TEM images, and energy dispersive X-ray spectroscopy (EDX). The antibacterial efficacy of AgNPs/DA against infectious pathogens for Tra catfish (Pangasianodon hypophthalmus), such as Aeromonas hydrophila and Edwardsiella ictaluri, was evaluated in this study. Keywords: antibacterial activity, nanocomposite, silver nanoparticles, electron beam, diatomite. |
TS. TRƯƠNG THỊ HẠNH (Nghiên cứu viên Viện Tiên tiến Khoa học và Công nghệ - Trường Đại học Văn Lang)
Nguồn: Tạp chí Công Thương